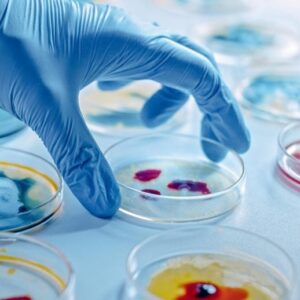
Ilmuwan mengambil cawan petri

Para ilmuwan telah mengembangkan partikel oksida logam kecil yang mendorong sel-sel kanker melampaui batas stres mereka dan tetap menjaga jaringan sehat. Sebuah tim internasional yang dipimpin oleh RMIT University telah baca >>
sebagian
Misteri yang sudah berusia seabad: Para ilmuwan mengukur sebagian kecil dari sebuah elektron, membuka kunci rahasia untuk katalisis
Penemuan ini dapat secara signifikan mengurangi biaya produksi bahan bakar, bahan kimia, dan bahan. Sebuah tim peneliti dari College of Science and Engineering University of Minnesota Twin Cities dan University baca >>
Sebagian besar energi gempa menjadi panas, bukan gemetar
Fotomikrograf elektron pemindaian menyoroti daerah batuan yang tergelincir selama gempa bumi yang diinduksi laboratorium. Area pusat “Flowy” mewakili sebagian dari batu yang meleleh dan berubah menjadi kaca karena pemanasan gesekan baca >>
Mengapa sebagian besar nutrisi tetap menjadi misteri
Makanan jauh lebih dari sekadar kalori dan nutrisi, ini adalah alam semesta kimia yang hampir tidak kita mulai memetakan. Membuka kunci “materi gelap gizi” ini dapat mengubah pemahaman kita tentang baca >>
Verizon akhirnya mengembalikan layanan di sebagian besar bidang setelah pemadaman sehari
Verizon mengatakan ribuan orang yang terkena dampak nasional oleh pemadaman besar -besaran sekarang memiliki layanan kembali. Jika ponsel Anda yang didukung Verizon keluar sebagian besar kemarin atau bahkan masih turun baca >>
Misteri Mikrobiologi: Mengapa sebagian besar mikroba mati di laboratorium?
Sebuah studi baru mengungkapkan bahwa keragaman mikroba dibentuk oleh jaringan saling ketergantungan. Ekosistem mikroba ditemukan di sekitar kita – di air laut, tanah, dan bahkan di dalam usus manusia – baca >>
Acara kepunahan massal awal memasak planet kita dan menghapus sebagian besar kehidupan
252 juta tahun yang lalu, letusan gunung berapi di Siberia modern memuntahkan 100 triliun metrik ton karbon dioksida (CO2) ke atmosfer selama rentang satu juta tahun. Bencana alam ini, yang baca >>